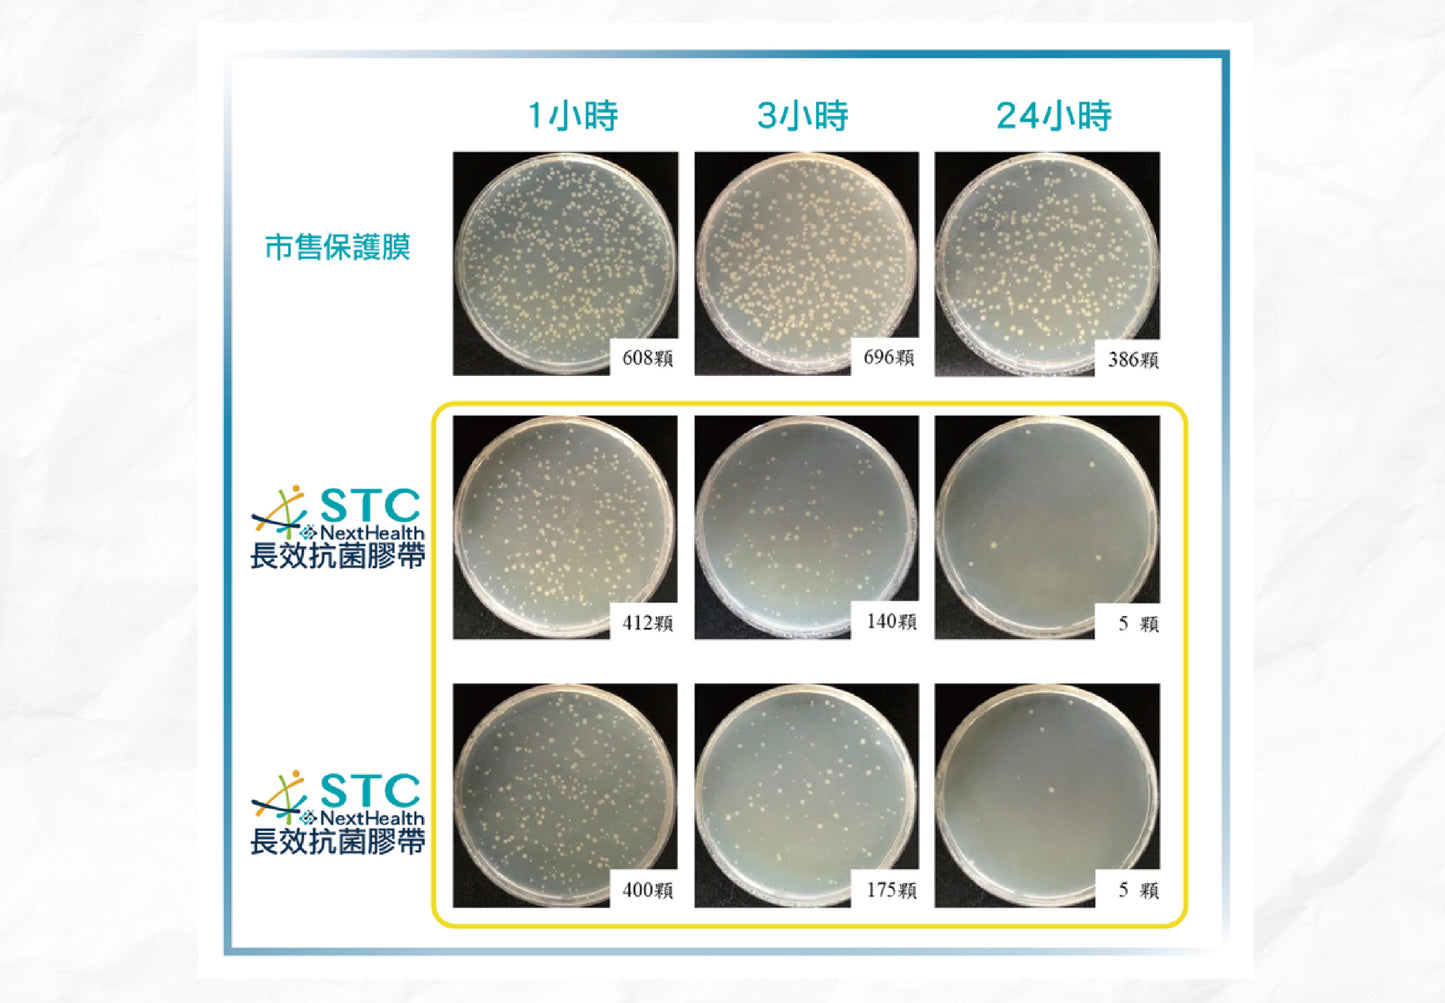

stcnanotech
STC 長效抗菌氧化鋅膠帶10公分寬
STC 長效抗菌氧化鋅膠帶10公分寬
定價
$399.00 TWD
定價
$399.00 TWD
售價
$399.00 TWD
單價
每
無法載入取貨服務供應情況
使用方法&注意事項
使用方法
1.將欲貼抗菌膠帶之表面,清潔乾淨。
2.將抗菌膠帶裁剪至適合大小。
3.撕除離型紙及貼附完成。
(註:如擔心貼不平,可在欲貼表面先噴一點水,貼完抗菌膠帶後,將水推掉後,靜置到水乾即完成。)
使用環境建議
適⽤於⾦屬、玻璃、塑膠、烤漆、貼⽪等各式平整表⾯。
• 扶⼿、⾨把、⾯板等時常觸摸表⾯。
• 公共空間中多⼈觸碰的表⾯。
注意事項
1.抗菌膠帶破損請盡早更換。
2.因抗菌膠帶屬於消耗品,除商品本身瑕疵外,故拆封使用後不接受退貨。
3.使用上有出現身體不適、過敏症狀,請立即停止使用。
4.膠帶表面印刷“抗菌 Antibacterial”字樣是為讓您更好辨別抗菌面。
*TPU及矽膠因材質特性孔隙微小,較有殘膠可能性,不建議貼附。
*免責聲明:抗菌膠帶本身有一定的黏度,請勿貼在絨毛、易掉漆、薄膜、貼紙及易損表面,避免造成不必要之損失。下單即代表同意此規範,如不慎貼附在上述環境表面造成財物損失,本司無責。 *本產品已投保保富邦產品責任險,最高理賠金額100萬元。